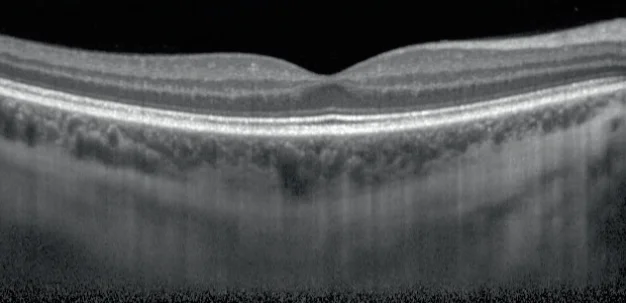
Normale Makula
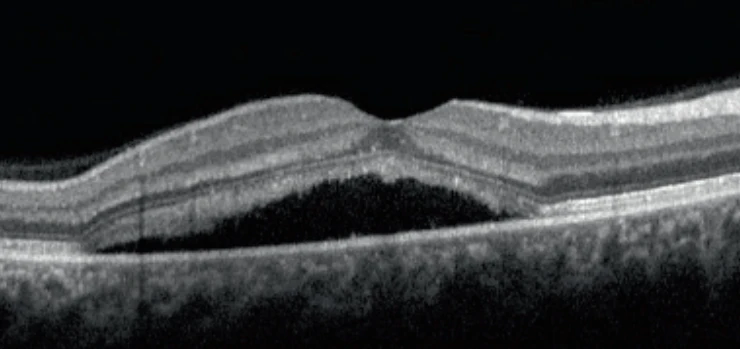
Retinopathia centralis serosa

Informatie
Links
Contact
De terugbeltijden zijn: maandag t/m donderdag van 8.30 uur tot 17.00 uur vrijdag 8.30 uur tot 13.00 uur

Zien zonder bril
Overige behandelingen
Zur Suche Text hier eingeben.
De terugbeltijden zijn: maandag t/m donderdag van 8.30 uur tot 17.00 uur vrijdag 8.30 uur tot 13.00 uur
Start » Oogaandoeningen » Netvliesaandoeningen » Retinopathie centralis serosa
De gezonde macula
Retinopathie centralis serosa (RCS) of chorioretinopathie centralis serosa (CCS) is een ophoping van vocht onder de zintuigcellenlaag van het netvlies. De oorzaken en mechanismen worden momenteel niet volledig begrepen, maar men vermoedt een gestoorde pompfunctie van het pigmentepitheel (RPE) onder de zintuiglijke cellen, die wordt veroorzaakt door een zwelling en overmatige permeabiliteit van de choroïdale vaten onder het getroffen gebied.
De ziekte, ook bekend als "managersziekte", komt vaker voor bij mannelijke patiënten van middelbare leeftijd en wordt vermoedelijk veroorzaakt door stress.

Retinopathie centralis serosa
Typische symptomen zijn frequent eenzijdig verlies van gezichtsscherpte, het optreden van metamorfopsie (vervormd zicht) en de waarneming van groenachtige of grijsachtige vlekken in het gezichtsveld.
Het verloop en dus ook de behandeling kan heel verschillend zijn. Vaak verdwijnt het oedeem binnen 3 maanden zonder therapie of met stressvermijding of -vermindering.
Als het oedeem langer dan 3-4 maanden aanhoudt, spreekt men van de chronische vorm. Er bestaat geen uniforme, op studies gebaseerde en dus evidence-based therapie voor de chronische vormen. Therapie met VEGF-remmers is niet veelbelovend. Anderzijds kunnen therapieën met laserbehandelingen en fthotodynamische therapie van lagere intensiteit (PDT met lage dosis of halve intensiteit) worden overwogen. De inmiddels gevolgde aanpak met tabletbehandeling met aldosteronantagonisten (bv. spironolacton of eplerenon) is in de huidige verklaring van onze beroepsverenigingen verlaten wegens gebrek aan doeltreffendheid in gerandomiseerde studies.

Het sicca syndroom is een veelvoorkomende aandoening die wordt veroorzaakt door een verminderde productie van

In de loop van het leven krijgt iedereen te maken met een inkrimping van het

Diabetes en het oog, diabetische retinopathie (netvliesaandoening) is vooral een aandoening van de kleine bloedvaten

Netvliesafwijking vroeggeborenen (prematuren retinopathie) ist ein Netzhauterkrankung, welche ein frühgeborenes Kind in seiner Behandlung der
Adding {{itemName}} to cart
Added {{itemName}} to cart
U bekijkt momenteel inhoud van een plaatshouder van Accessibility Widget. Klik op de knop hieronder om de volledige inhoud te bekijken. Houd er rekening mee dat u op deze manier gegevens deelt met providers van derden.
Meer informatieU bekijkt momenteel inhoud van een plaatshouder van Vimeo. Klik op de knop hieronder om de volledige inhoud te bekijken. Houd er rekening mee dat u op deze manier gegevens deelt met providers van derden.
Meer informatieU bekijkt momenteel inhoud van een plaatshouder van YouTube. Klik op de knop hieronder om de volledige inhoud te bekijken. Houd er rekening mee dat u op deze manier gegevens deelt met providers van derden.
Meer informatieOm het formulier te verzenden, moet u inhoud laden van reCAPTCHA. Houd er rekening mee dat u op deze manier gegevens deelt met providers van derden.
Meer informatie